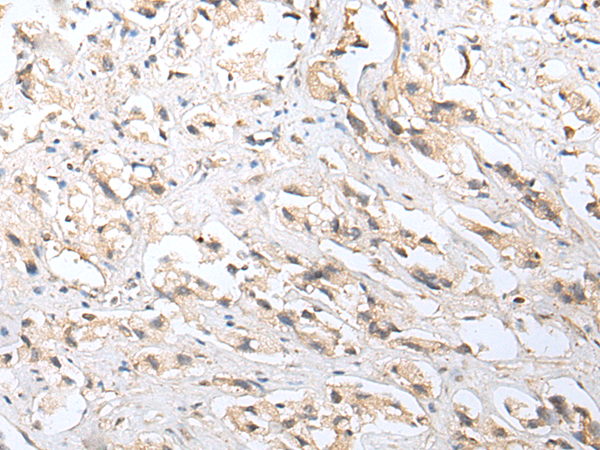

别名:YSA1; YSA1H; YSAH1; hYSAH1应用:WB,IHC
反应种属:Human, Mouse, Rat
规格:50μl/100μl
| Description |
|---|
| This gene belongs to the Nudix (nucleoside diphosphate linked moiety X) hydrolase superfamily. The encoded enzyme catalyzes the hydrolysis of modified nucleoside diphosphates, including ADP-ribose (ADPR) and 8-oxoGua-containing 8-oxo-dADP and 8-oxo-dGDP. Protein-bound ADP ribose can be hazardous to the cell because it can modify some amino acid residues, resulting in the inhibition of ATP-activated potassium channels. 8-oxoGua is an oxidized form of guanine that can potentially alter genetic information by pairing with adenine and cytosine in RNA. |
| Specification | |
|---|---|
| Aliases | YSA1; YSA1H; YSAH1; hYSAH1 |
| Swissprot | Q9UKK9 |
| WB Predicted band size | 24 kDa |
| Host/Isotype | Rabbit IgG |
| Storage | Store at 4°C short term. Aliquot and store at -20°C long term. Avoid freeze/thaw cycles. |
| Species Reactivity | Human, Mouse, Rat |
| Immunogen | Synthetic peptide of human NUDT5 |
| Formulation | pH7.4 PBS, 0.05% NaN3, 40% Glycerol |
| Application | |
|---|---|
| WB | 1/200-1/1000 |
| IHC | 1/10-1/50 |
| ELISA | 1/5000-1/10000 |
![]() |
Gel: 12%SDS-PAGE, Lysate: 40 μg, Lane: A431 cell, Primary antibody: P12633(NUDT5 Antibody) at dilution 1/200, Secondary antibody: Goat anti rabbit IgG at 1/8000 dilution, Exposure time: 1 minute |
![]() |
The image is immunohistochemistry of paraffin-embedded Human prostate cancer tissue using P12633(NUDT5 Antibody) at dilution 1/20. (Original magnification: ×200) |
本公司的所有产品仅用于科学研究或者工业应用等非医疗目的,不可用于人类或动物的临床诊断或治疗,非药用,非食用。
暂无评论
本公司的所有产品仅用于科学研究或者工业应用等非医疗目的,不可用于人类或动物的临床诊断或治疗,非药用,非食用。
中文

发表回复